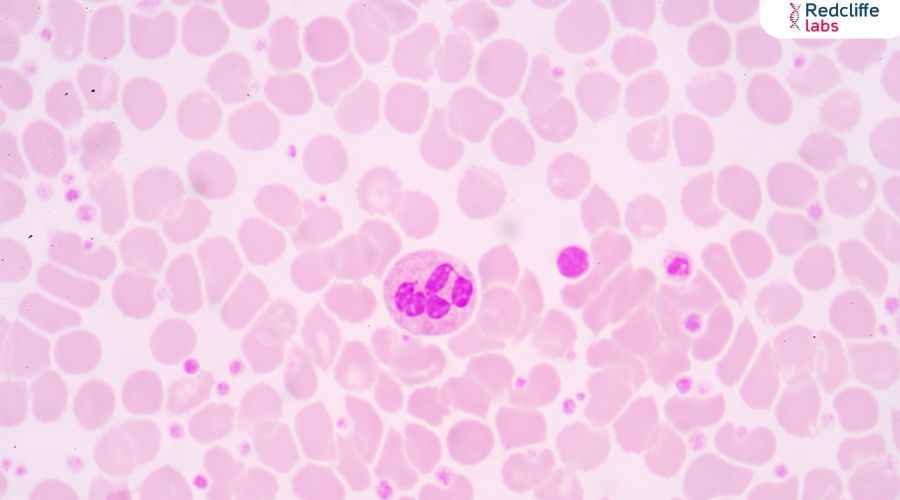
https://myhealth-redcliffelabs.redcliffelabs.com/media/blogcard-images/None/754b33a0-dd6d-4ec9-9649-91a29bbff3da.webp

Platelets Meaning in Marathi: काय आहेत आणि त्यांचे कार्य काय आहे?

Medically Reviewed By
Dr. Geetanjali Gupta
Written By Komal Daryani
on Aug 30, 2024
Last Edit Made By Komal Daryani
on Jul 19, 2025
प्लेटलेट्स म्हणजे रक्तातील लहान, रंगहीन पेशी तुकडे आहेत जे रक्तस्त्राव थांबवण्यासाठी आणि जखमा बरे करण्यासाठी महत्त्वपूर्ण भूमिका बजावतात. रक्तवाहिन्या फुटल्यास किंवा जखम झाल्यास, प्लेटलेट्स झटपट त्या ठिकाणी गोळा होतात आणि चिकटून राहून रक्तस्त्राव थांबवतात. त्यांची ही क्षमता हेमोस्टॅसिस प्रक्रियेतून रक्तस्त्राव रोखण्यास मदत करते. प्लेटलेट्सची योग्य संख्या आणि कार्यक्षमता आरोग्यासाठी अत्यावश्यक आहे, कारण त्यांच्या कार्यात त्रुटी आल्यास गंभीर आरोग्य समस्या निर्माण होऊ शकतात. त्यामुळे, प्लेटलेट्सचे महत्त्व लक्षात घेणे आणि त्यांची काळजी घेणे आवश्यक आहे.
प्लेटलेट्सची रचना आणि उत्पत्ती
प्लेटलेट्स हे लहान, रंगहीन आणि डिस्कच्या आकाराचे पेशी तुकडे आहेत. त्यांची निर्मिती अस्थिमज्जेमधील मेगाकारियोसायट्स नावाच्या मोठ्या पेशींमधून होते. मेगाकारियोसायट्स तुटल्यामुळे प्लेटलेट्स तयार होतात आणि रक्तप्रवाहात सोडल्या जातात. प्लेटलेट्समध्ये ग्रॅन्यूल्स असतात ज्यामध्ये विविध रसायने आणि प्रथिने असतात, जी रक्तजमा आणि जखमांच्या बरे होण्याच्या प्रक्रियेत महत्त्वाची भूमिका बजावतात. प्रत्येक प्लेटलेटचा आयुष्यकाळ साधारणत ७ - १० दिवस असतो, त्यानंतर नवीन प्लेटलेट्स त्यांची जागा घेतात. हाडांच्या मज्जेतून सतत तयार होणाऱ्या या प्लेटलेट्समुळे शरीरात रक्तस्त्राव होण्यापासून बचाव होतो आणि जखमांमुळे होणारे नुकसान कमी होते.
प्लेटलेट्सची कार्ये
प्लेटलेट्सची मुख्य भूमिका हेमोस्टॅसिस प्रक्रियेत असते, जी रक्तस्त्राव थांबवण्याची प्रक्रिया आहे. रक्तवाहिनी फुटल्यावर, प्लेटलेट्स झटपट जखमेच्या ठिकाणी गोळा होतात. त्या ठिकाणी ते चिकटून एकमेकांना जोडून प्लेटलेट प्लग तयार करतात, ज्यामुळे रक्तस्त्राव थांबतो.
ही प्रक्रिया प्राथमिक हेमोस्टॅसिस म्हणून ओळखली जाते.
पुढील टप्पा म्हणजे रक्तजमा होणे, ज्याला द्वितीयक हेमोस्टॅसिस म्हणतात. प्लेटलेट्स सक्रिय झाल्यावर त्यांच्यातील ग्रॅन्यूल्समधून विविध रसायने, जसे की ADP, थ्रोम्बॉक्सेन आणि सेरोटोनिन, सोडली जातात. ही रसायने इतर प्लेटलेट्सना आकर्षित करून त्यांना सक्रिय करतात, ज्यामुळे अधिक प्लेटलेट्स जखमेच्या ठिकाणी येतात आणि एकत्र होतात. या प्रक्रियेला प्लेटलेट एकत्रीकरण म्हणतात.
या दरम्यान, रक्ताच्या प्लाझमामध्ये उपस्थित क्लॉटिंग फॅक्टर्स सक्रिय होतात आणि फायब्रिन नावाचे प्रथिन तयार होऊन एक जाळे तयार करते. या जाळ्यात प्लेटलेट्स अडकतात आणि रक्तजमा तयार होतो, ज्यामुळे रक्तस्त्राव पूर्णपणे थांबतो.
प्लेटलेट्स जखमांच्या बरे होण्याच्या प्रक्रियेतही महत्वाची भूमिका बजावतात. त्यांच्या ग्रॅन्यूल्समध्ये विविध वृद्धी घटक असतात, जसे की प्लेटलेट- डेराइव्ड ग्रोथ फॅक्टर (PDGF) आणि ट्रान्सफॉर्मिंग ग्रोथ फॅक्टर बीटा (TGF- β), जे ऊतकांचे पुनर्निर्माण आणि जखमांच्या बरे होण्यास मदत करतात. या घटकांमुळे नवीन पेशींची निर्मिती होते आणि जखम लवकर बरी होते. अशा प्रकारे, प्लेटलेट्स रक्तस्त्राव रोखण्यासोबतच शरीरातील जखमा बऱ्या करण्याचे महत्त्वपूर्ण कार्य करतात.
प्लेटलेट विकार
प्लेटलेट विकार हे प्लेटलेट्सच्या संख्येत किंवा त्यांच्या कार्यात असलेल्या असामान्यतेमुळे उद्भवतात. थ्रोम्बोसाइटोपेनिया, थ्रोम्बोसाइटोसिस, आणि प्लेटलेट कार्य विकार हे मुख्य प्रकार आहेत. थ्रोम्बोसाइटोपेनिया कारणे आणि परिणाम थ्रोम्बोसाइटोपेनिया म्हणजे प्लेटलेट्सची संख्या कमी असणे. याचे कारण विविध असू शकते, जसे की ऑटोइम्यून विकार, काही औषधे, विषाणूजन्य संक्रमण, किंवा अस्थिमज्जेचे विकार.
कमी प्लेटलेट्समुळे रक्तस्त्राव होण्याची शक्यता वाढते, ज्यामुळे नाकातून किंवा गुदद्वारातून रक्तस्त्राव, चट्टे आणि पुरळ होऊ शकतात. गंभीर थ्रोम्बोसाइटोपेनिया असलेल्या रूग्णांना अंतर्गत रक्तस्त्राव होण्याची शक्यता जास्त असते. थ्रोम्बोसाइटोसिस कारणे आणि परिणाम थ्रोम्बोसाइटोसिस म्हणजे प्लेटलेट्सची संख्या जास्त असणे. हे अस्थिमज्जेतील मेगाकारियोसायट्सच्या असामान्य वाढीमुळे होऊ शकते. याचे कारण कर्करोग, प्रदाहजन्य विकार किंवा काही अनुवंशिक विकार असू शकतात.
थ्रोम्बोसाइटोसिसमुळे रक्ताच्या थक्क्यांची शक्यता वाढते, ज्यामुळे स्ट्रोक, हार्ट अटॅक आणि डीप व्हेन थ्रोम्बोसिस सारख्या गंभीर समस्यांचा धोका वाढतो. प्लेटलेट कार्य विकार प्रकार आणि लक्षणे प्लेटलेट कार्य विकार हे प्लेटलेट्सच्या कार्यक्षमतेत असलेल्या त्रुटीमुळे उद्भवतात. हेमोफिलिया, ग्लॅन्झमन थ्रोम्बोस्थेनिया, आणि बर्नार्ड- सोलिअर सिंड्रोम हे काही उदाहरणे आहेत. या विकारांमध्ये प्लेटलेट्स व्यवस्थितपणे एकत्र येत नाहीत किंवा कार्यरत होत नाहीत, ज्यामुळे रक्तस्त्राव होतो.
लक्षणांमध्ये दीर्घकाळ रक्तस्त्राव, छोटे चट्टे, आणि जखमांमुळे रक्तस्त्राव थांबत नसणे यांचा समावेश होतो. प्लेटलेट विकारांमुळे उद्भवणाऱ्या समस्या गंभीर असू शकतात, त्यामुळे त्यांचे निदान आणि उपचार करण्यासाठी योग्य वैद्यकीय सल्ला आवश्यक असतो.
प्लेटलेट्सच्या चाचण्या
प्लेटलेट विकारांचे निदान करण्यासाठी विविध चाचण्या केल्या जातात. प्लेटलेट काउंट चाचणी ही चाचणी प्लेटलेट्सची संख्या मोजते. सामान्यत प्रति मायक्रोलीटर रक्तात 150,000 ते 450,000 प्लेटलेट्स असतात. या चाचणीद्वारे थ्रोम्बोसाइटोपेनिया किंवा थ्रोम्बोसाइटोसिसचे निदान होते.
प्लेटलेट फंक्शन चाचणी ही चाचणी प्लेटलेट्सच्या कार्यक्षमतेची तपासणी करते. यात प्लेटलेट्स कसे एकत्र येतात आणि रक्तजमा कसा तयार करतात हे तपासले जाते. प्लेटलेट एग्रीगेशन चाचणी आणि क्लॉट रिट्रॅक्शन चाचणी यांचा यात समावेश होतो.
बोन मॅरो चाचणी थ्रोम्बोसाइटोपेनिया किंवा थ्रोम्बोसाइटोसिसच्या कारणांचे निदान करण्यासाठी हाडांच्या मज्जेतून नमुना घेतला जातो. ही चाचणी अस्थिमज्जेच्या स्थितीचे आणि त्यामधील मेगाकारियोसायट्सचे निरीक्षण करते, ज्यामुळे प्लेटलेट्सच्या निर्मितीची माहिती मिळते. या चाचण्यांमुळे प्लेटलेट विकारांचे अचूक निदान होऊ शकते, ज्यामुळे योग्य उपचारांची आखणी करता येते. योग्य निदान आणि उपचारांमुळे प्लेटलेट्ससंबंधित समस्यांचा प्रभावीपणे सामना करता येतो.
प्लेटलेट विकारांचे उपचार
थ्रोम्बोसाइटोपेनियासाठी उपचार थ्रोम्बोसाइटोपेनियाच्या उपचारांमध्ये त्याचे कारण ओळखून योग्य उपाययोजना केल्या जातात. ऑटोइम्यून थ्रोम्बोसाइटोपेनिक पर्पुरा (ITP) मध्ये स्टेरॉइड्स किंवा इम्यूनोसप्रेसिव्ह औषधे दिली जातात. गंभीर स्थितींमध्ये प्लेटलेट ट्रान्सफ्युजन आवश्यक असू शकते, ज्यामुळे प्लेटलेट्सची संख्या त्वरित वाढवता येते. थ्रोम्बोसाइटोसिससाठी उपचार थ्रोम्बोसाइटोसिसच्या उपचारांमध्ये प्लेटलेट्सची संख्या कमी करण्यासाठी औषधे दिली जातात.
हायड्रोक्सीयुरिया आणि अॅनाग्रिलाइड ही सामान्यतः वापरली जाणारी औषधे आहेत. तसेच, अँटीकोआगुलंट्स दिले जातात, जे रक्ताच्या थक्क्यांची शक्यता कमी करतात. प्लेटलेट कार्य विकारांचे व्यवस्थापन प्लेटलेट कार्य विकारांसाठी विशिष्ट उपचार उपलब्ध आहेत.
हेमोफिलिया सारख्या विकारांमध्ये क्लॉटिंग फॅक्टर बदलाने उपचार केले जातात. इतर विकारांमध्ये औषधे किंवा प्लेटलेट ट्रान्सफ्युजन दिले जाऊ शकतात, ज्यामुळे प्लेटलेट्सची कार्यक्षमता सुधारली जाते. योग्य निदान आणि उपचारांच्या मदतीने प्लेटलेट विकारांमुळे उद्भवणाऱ्या समस्यांवर प्रभावीपणे नियंत्रण ठेवता येते. त्यामुळे, डॉक्टरांच्या सल्ल्याने योग्य उपचार करणे अत्यावश्यक आहे.
प्लेटलेट्सची काळजी कशी घ्यावी?
आहार आणि जीवनशैली प्लेटलेट्सच्या आरोग्यासाठी संतुलित आहार आणि नियमित जीवनशैली महत्त्वाची आहे. आहारात आयरन, फॉलिक अॅसिड, आणि विटॅमिन B12 यांचा समावेश असावा, कारण हे घटक प्लेटलेट्सच्या निर्मितीसाठी आवश्यक असतात. पालेभाज्या, फळे, आणि संपूर्ण धान्य यांचा समावेश असलेले अन्न खाणे फायद्याचे ठरते. कमी साखर, कमी मीठ, आणि कमी चरबीचा आहार प्लेटलेट्सच्या कार्यक्षमतेला उत्तेजित करतो.
प्लेटलेट्सच्या आरोग्यासाठी टिप्स नियमित व्यायाम, विशेषतः कार्डियोवास्कुलर व्यायाम, रक्त संचार सुधारतो आणि प्लेटलेट्सच्या कार्यक्षमतेला मदत करतो. अधिक पाणी पिणे आणि धूम्रपान किंवा मद्यपान टाळणे देखील महत्त्वाचे आहे, कारण हे शरीराच्या सामान्य कार्यक्षमतेवर विपरीत परिणाम करू शकते. नियमित वैद्यकीय तपासणी करणे आणि प्लेटलेट्सची संख्या आणि कार्यक्षमता तपासणे, विकारांची प्रारंभिक स्थितीत ओळख करून त्यावर योग्य उपचार करणे आवश्यक आहे.
निष्कर्ष
प्लेटलेट्स हे रक्तस्त्राव रोखणे आणि जखम भरून काढण्यासाठी अत्यावश्यक घटक आहेत. त्यांच्या असामान्यतेमुळे गंभीर आरोग्य समस्या निर्माण होऊ शकतात. योग्य निदान, उपचार आणि आरोग्यदायी जीवनशैलीने प्लेटलेट्सचे आरोग्य राखणे महत्त्वाचे आहे, ज्यामुळे आपले शरीर निरोगी राहते.


